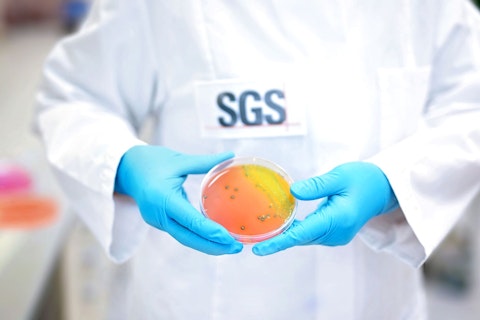
SGS Microbiology Services Lab Scientist Holding Specimen

News Type
Publication Date
Topic
2782 results found

Qiangsheng New Materials Receives GHG and PCF Verification
Qiangsheng New Materials receives verification for GHG emissions and product carbon footprints, advancing its sustainability leadership.
Read more
Why Outsourcing Quality Control Makes Sense for Cosmetics
Exploring how outsourced cosmetic quality control boosts compliance, reduces costs and accelerates safe, market-ready product development.
Read more
Japanese Consumer Product Safety Act (CPSA) comes into force
For infant toys new requirements apply after December 25, 2025.
Read more
The Netherlands Modifies Law on Food Contact Materials
The Netherlands has revised its Commodities Act on food contact materials (FCMs) and articles.
Read more
EU Proposes Ban on Three POP Chemicals
EU consults over three draft laws to revise legislation on persistent organic pollutants (POPs).
Read more
Health Canada Updates Table 2 of the General Prohibitions Process under the CCPSA
Health Canada adds button/coin battery-containing products and packaging to Table 2 CCPSA General Prohibitions.
Read more
Washington, USA, Regulates PFAS in Consumer Goods
US state of Washington adopts rule to regulate PFAS in 12 priority consumer products.
Read more
EU Proposes Revision to CLP Regulation on Substances and Mixtures
EU issues revision to CLP Regulation, adding 38 substances and updating 10 entries.
Read more
SGS Recognized for Excellence in Safety by Vivo Energy Kenya
SGS in Kenya has been honored with a prestigious safety award for enhancing work-at-height measures during tank meter calibration.
Read more
World’s First ISO/IEC 5259-3 Certification for AI Data Quality Management
AI Clearing achieves the world’s first ISO/IEC 5259-3 certificate following a thorough audit process.
Read more